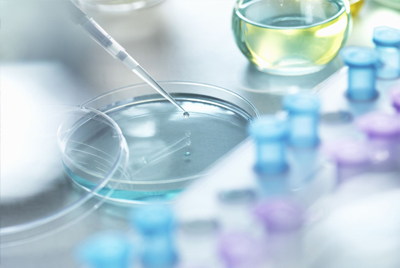
Laboratory Equipment

Welcome to
Tillo Co. Ltd
Helps customers around the globe to deliver quality health care by delivering the products they want, with the quality they demand and the value they need.
Tillo Co Ltd can supply leading brands of laboratory products including Fisher Scientific, SciLabware, Schott Duran, Julabo, Grants Instruments, Hanna Instruments, Jenway, Mettler Toledo, Ohaus and many more.
We distributes a vast range of medical and surgical products to healthcare, academia institutions and retail markets around the globe.
Our Mission:
1- To provide quality medical products with superior value to healthcare providers and end users.
2- Improving patient care and enhancing the quality of peoples’ lives.
Products:
Laboratory Equipment
Expertise and tools for basic research of cells and biomolecules, as well as tools for drug discovery and cell therapy research including: Analysis Devices, Blood Sugar Monitors, Coagulometers, Lactometers, Microscopes.

Diagnostic Development
Wide selection of technologies and solutions researchers involved in therapeutic and diagnostic development: Diagnostic Membranes, Chromatography, DNA Analysis.

Medical Instruments
Huge selection of medical instruments for diverse disciplines. Whether you need forceps, scalpel handles, retractors or needle holders, we can supply the proper instruments to suit your needs.
Contact Tillo Co. Ltd
Address: 4 Waverley Lodge, 22 Waverley Road, Southampton,SO15 1JG, UK
Email: Info@Tillo-Co.com